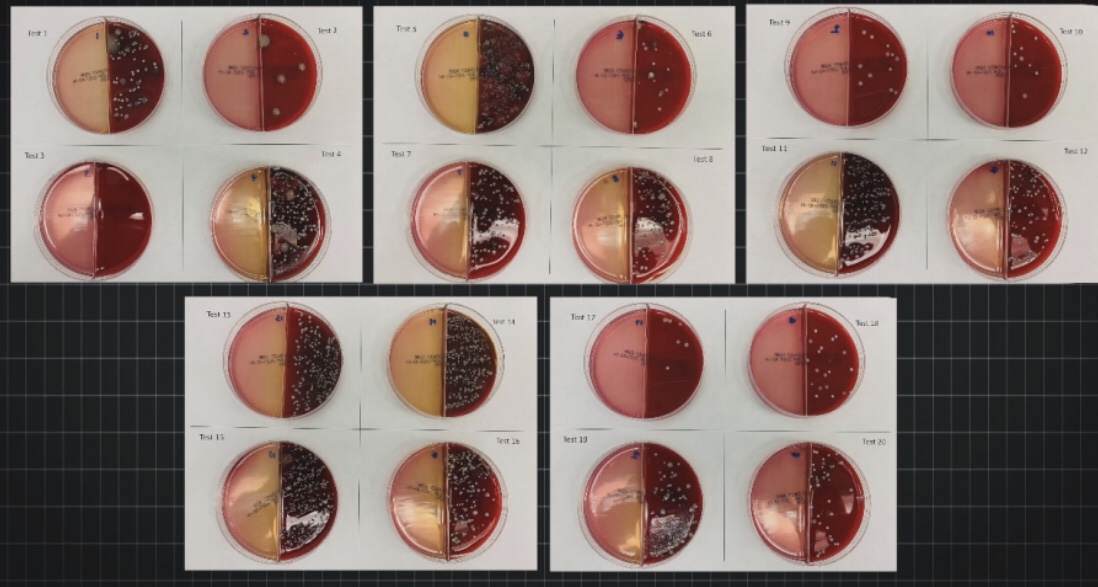
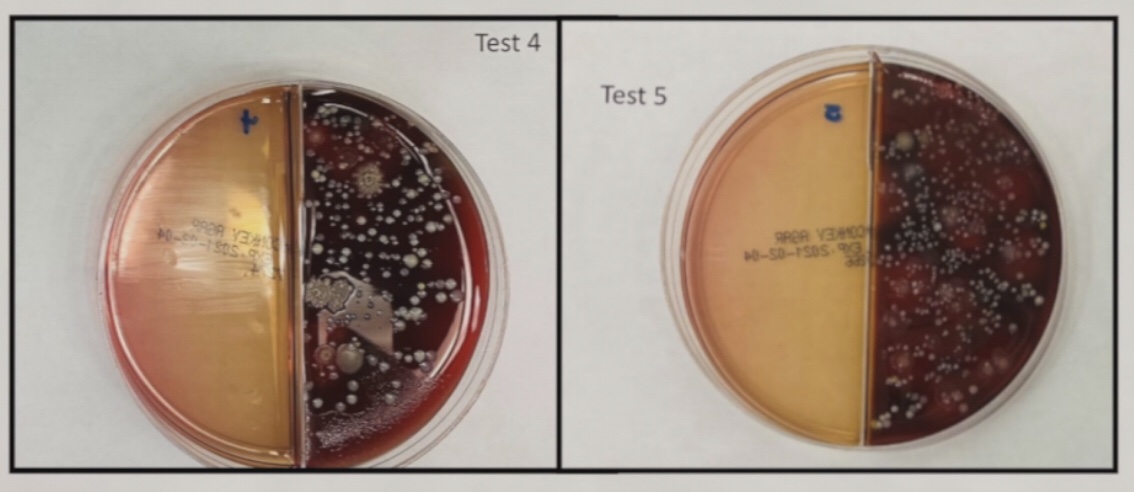

Not me. Not you. God does that.
“A farmer went out to sow his seed. 4 As he was scattering the seed, some fell along the path, and the birds came and ate it up. 5 Some fell on rocky places, where it did not have much soil. It sprang up quickly, because the soil was shallow. 6 But when the sun came up, the plants were scorched, and they withered because they had no root. 7 Other seed fell among thorns, which grew up and choked the plants. 8 Still other seed fell on good soil, where it produced a crop—a hundred, sixty or thirty times what was sown.
Matthew 13:3-8
There are things we can do to help a seed, whether real or metaphorical, grow. However, the decision, is ultimately God’s.
This plain fact of life is something it seems we need to collectively remember. When a person subjects themself to increased bacterial growth through wearing a face mask, or chooses to be injected with a new medical treatment with almost zero historical recording of reactions, despite their beliefs, they are not masked crusaders saving the day.

Rather, they are rather something more along the lines of this guy:

Of course, we have all been subjected to billions of dollars in advertising, bombarding us with images and text every day, to convince us otherwise.
Rather than heroism, these choices put those around you at greater risk. No one wants to be the bad guy, but it’s possible that millions of of Americans have been tricked into fulfilling that role.

Carrying a bit of cloth covered in bacterial and fungal growth with you everywhere you go, means we are all at greater risk of ill health.
For example, Streptococcus lives happily inside of you. “Strep throat lives in your tonsils.” If however, you cough it into a mask and then allow that streptococcus to grow in a warm, dark moist environment, then spread it to your skin, and to a door knob where other people will get it on their skin… well that’s where your “heroic act” becomes a threat, especially to the vulnerable populations you are trying to protect.
Similarly, an injection designed to be self-disseminating from those that choose to have this treatment to those that specifically did not chose this treatment, again places the whole of our society at risk.

The above image is from Trends in Microbiology 2018. The article covers the history of transmissible (spreading, self-disseminating) vaccines, through the then current technologies and the best option for creating new ones. Funnily enough, the current technology is exactly what was considered the best, most transmissible option.
Of course if you Google “Does the Covid vaccine shed?” You will easily discover from the headlines that it does not. Yet, it was from reading these articles and their supporting research that I found the above 2018 Trends in Microbiology article that not only lays out plans for improving transmissible vaccines but also explains that we already have multiple transmissible vaccines, the most notable being the polio vaccine.
We all know that no one wearing a mask or ‘getting the jab’ is trying to hurt anyone. You’re not laying out plans for world domination. You’re not luring famous heroes to a remote island to create an invincible robot.

Many are, however, taking on the mantle of savior. They are buying into the lie of human power over life and death. The lie that the simple acts of restricting your breathing or rolling up your sleeve is going to save people. These acts are much, much easier than doing your own research or even simply following the money. The images on your screen tell you that your action saved everyone.
Yet, we forget, to check the truth found in the Word of God. The truth that God alone has power over life and death. When we try to take on the power of God, we ultimately fail, every time. Yes, there are things we can do to support the cause of life, but wearing a mask or accepting a biological product has no effect on God’s power. (Please note that masks and jabs do not support the cause of life.) However, the decision is ultimately God’s.
God saves. Not me. Not you. Not your mask. Not your jab. God does that.